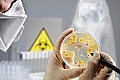

Отставка премьер-министра Николая Азарова возможна. В окружении Президента Кабмин обвиняют в косности и в нежелании брать на себя ответственность за реформы.

В пятницу, 10 июня, в Украине переменная облачность, местами кратковременные дожди, гроза, температура воздуха днем +26…+28 градусов. В пятницу, 10 июня, в Киеве переменная облачность, ночью без осадков.

Одна из проблем деловых незамужних женщин в Киеве - они не могут найти себе спутника жизни. Вне зависимости от возраста, занятые бизнес-леди проводят все время на работе, да и знакомиться с первым встречным не годится.
Мариупольская милиция предварительно установила, что в городе были нарушены санитарные правила по предупреждению эпидемических заболеваний.

Популярная украинская певица Ани Лорак и ее супруг турецкий бизнесмен Мурат стали счастливыми родителями. Артистка родила своего первенца – девочку весом 3,29 килограмма, ростом – 52 сантиметра.

Российскую журналистку, которая приехала в Лисью бухту, избили и несколько раз изнасиловали на пляже и в лесу двое местных пастухов. В районе Лисьей бухты под Феодосией (Крым) двое местных пастухов избили.

Для удобства налогоплательщиков телефоны доверия налоговой службы, которые функционировали во всех регионах Украины, будут иметь единый номер 0-800-501-007 (для жителей Киева (044) 454-16-13).

У Президента Украины Виктора Януковича появилась новая радость в жизни – по эксклюзивному заказу для "Межигорья" был построен уникальный в своем роде "Дворец на воде".

Россия ограничила поставки электроэнергии в Белоруссию за долги, сообщил источник в компании "Интер РАО" - российском экспортере электроэнергии. Ограничение составит 200 МВт.

Экстренные службы Польши устраняют последствия мощного циклона. Проливные дожди шли всего пару часов, но этого было достаточно, чтобы затопить несколько населенных пунктов.